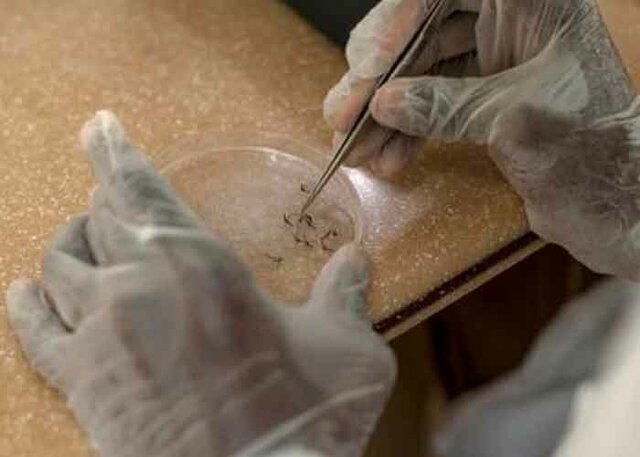
EDAD CONTEMPORANEA

-
 Se hizo alusión al fruto de la adormidera Papaver
Se hizo alusión al fruto de la adormidera Papaver
somniferum -
 Pen Tsao o Gran herbario fue el primer médico de ese país, se le atribuye el descubrimiento de diferentes drogas y venenos, así como la identificación de cientos de plantas medicinales y venenosas.
Pen Tsao o Gran herbario fue el primer médico de ese país, se le atribuye el descubrimiento de diferentes drogas y venenos, así como la identificación de cientos de plantas medicinales y venenosas. -
 Bajo la dominación sumeria, se describieron conocimientos
Bajo la dominación sumeria, se describieron conocimientos
sobre el ranúnculo (Ranunculus bulbosus, R. peltatus, R. repens), euphorbia (Euphorbia antiquorum, E. resinifera, E. officinarum) y la belladona (Atropa belladonna) en Mesopotamia. -
 En el libro de la Ciencia de la Vida (Ayurveda), se describen
En el libro de la Ciencia de la Vida (Ayurveda), se describen
ocho disciplinas diferentes, como la Toxicología (Agada tantra); se citan algunos venenos vegetales como oleandro, y minerales como el arsénico y el mercurio. -
 En el año 400 a.n.e, se reportó el uso de venenos de origen vegetal y de animales.
En el año 400 a.n.e, se reportó el uso de venenos de origen vegetal y de animales.
Aristóteles (384-322 a.n.e), por más de dos milenios, apuntó el uso de veneno de víboras. -
 Pedacio Dioscórides hizo un interesante aporte toxicológico en su
Pedacio Dioscórides hizo un interesante aporte toxicológico en su
De Universa Medica al discutir sobre venenos y antídotos; los agrupó según su origen vegetal, animal o mineral, y habló sobre la importancia de la evacuación del tóxico por los más propicios lugares antes que cobre fuerzas. -
 En la Roma antigua, el veneno estaba principalmente en manos de los poderosos: generales, políticos y aristócratas
En la Roma antigua, el veneno estaba principalmente en manos de los poderosos: generales, políticos y aristócratas -
 Jabir Ibn Haiyan a comienzos del X, señala que las
Jabir Ibn Haiyan a comienzos del X, señala que las
emanaciones de oro resecan la nariz y pueden dañar el cerebro, Fue el primero en describir los ácidos minerales fuertes, como el ácido sulfúrico y el nítrico. -
 Al Razi escribió un texto en el que resumía el comportamiento de diversas sales y compuestos minerales y metálicos, como el azufre y el mercurio, y mencionó la theriaca.
Al Razi escribió un texto en el que resumía el comportamiento de diversas sales y compuestos minerales y metálicos, como el azufre y el mercurio, y mencionó la theriaca. -
 Abú Mansur Muwaffaw expuso conocimientos de Toxicología, fundamentalmente los efectos tóxicos de los compuestos de cobre y plomo.
Abú Mansur Muwaffaw expuso conocimientos de Toxicología, fundamentalmente los efectos tóxicos de los compuestos de cobre y plomo. -
 En esta época se siente la necesidad de establecer una Toxicología de carácter médico-legal, se destacaron Avicena quien recogió en El Canon de Medicina la intoxicación por opio (Papaver somniferum) y Maimónides describe por primera vez en su libro que para tratar la picadura de serpiente se debía succionar el veneno.
En esta época se siente la necesidad de establecer una Toxicología de carácter médico-legal, se destacaron Avicena quien recogió en El Canon de Medicina la intoxicación por opio (Papaver somniferum) y Maimónides describe por primera vez en su libro que para tratar la picadura de serpiente se debía succionar el veneno. -
 En el siglo XV existió en Venecia el Consejo de los Diez, el cual establecía un listado de víctimas que en dependencia del rango social y la dificultad de aproximación a esta se determinaba el precio de los envenenamientos.
En el siglo XV existió en Venecia el Consejo de los Diez, el cual establecía un listado de víctimas que en dependencia del rango social y la dificultad de aproximación a esta se determinaba el precio de los envenenamientos. -
 La historia de la Toxicología recoge el nombre de famosas
La historia de la Toxicología recoge el nombre de famosas
mujeres envenenadoras como Lucrecia Borgia, Madame Toffana, Catalina de Médicis, etc. -
 El veneno invade igualmente la literatura, es paradigma de ello el Hamlet de Shakespeare.
El veneno invade igualmente la literatura, es paradigma de ello el Hamlet de Shakespeare. -
 Los países sometidos al cristianismo se oponían, con su filosofía eclesiástica, al progreso de las ciencias naturales y son los árabes los que empiezan a desarrollar la Toxicología.
Los países sometidos al cristianismo se oponían, con su filosofía eclesiástica, al progreso de las ciencias naturales y son los árabes los que empiezan a desarrollar la Toxicología. -
 Paracelso(1494-1541) fue pionero en emplear el concepto de dosis con sentido cuantitativo y desarrolló trabajos sobre el éter y la y atroquímica. Se anticipó a señalar la posibilidad de que ciertos venenos administrados a dosis adecuadas podían actuar como medicamentos. Fue el primero en describir y nombrar el zinc (zincum).
Paracelso(1494-1541) fue pionero en emplear el concepto de dosis con sentido cuantitativo y desarrolló trabajos sobre el éter y la y atroquímica. Se anticipó a señalar la posibilidad de que ciertos venenos administrados a dosis adecuadas podían actuar como medicamentos. Fue el primero en describir y nombrar el zinc (zincum). -
 Ellenbog (siglo xv) en 1480 alertó sobre la peligrosidad de la exposición al mercurio y al plomo relacionado con los procesos de orfebrería. Bacci Andrés (Ancona 1524-Roma 24 de octubre de 1600)publicó varias obras, entre las que se destacan, por su
Ellenbog (siglo xv) en 1480 alertó sobre la peligrosidad de la exposición al mercurio y al plomo relacionado con los procesos de orfebrería. Bacci Andrés (Ancona 1524-Roma 24 de octubre de 1600)publicó varias obras, entre las que se destacan, por su
relación con la Toxicología. -
 En el siglo XVIII, la frecuencia de envenenamientos en Francia hizo que las autoridades comenzaran a designar a peritos médicos y químicos, por lo que se dictó la ley que obligaba a recurrir a tales asesoramientos, nació así la Toxicología Judicial o Forense.
En el siglo XVIII, la frecuencia de envenenamientos en Francia hizo que las autoridades comenzaran a designar a peritos médicos y químicos, por lo que se dictó la ley que obligaba a recurrir a tales asesoramientos, nació así la Toxicología Judicial o Forense. -
 Bernardo Rammazzini inicia el estudio de las patologías relacionadas con el ejercicio profesional, puede considerarse el padre de la Medicina del Trabajo.
Bernardo Rammazzini inicia el estudio de las patologías relacionadas con el ejercicio profesional, puede considerarse el padre de la Medicina del Trabajo. -
Con el desarrollo de la ciencia, el veneno se difunde
Con el desarrollo de la ciencia, el veneno se difunde
entre todos los estratos sociales y se comienza a estudiar desde un punto de vista científico. -
 En 1836, Marsh estudió los datos de Orfila e ideó un sistema para investigar el arsénico como veneno en los homicidios, por eso este tóxico comenzó a perder la hegemonía como primera opción en los envenenamientos homicidas.
En 1836, Marsh estudió los datos de Orfila e ideó un sistema para investigar el arsénico como veneno en los homicidios, por eso este tóxico comenzó a perder la hegemonía como primera opción en los envenenamientos homicidas. -
 La Toxicología como ciencia dio sus primeros pasos en el área de la Medicina Legal y Judicial.
La Toxicología como ciencia dio sus primeros pasos en el área de la Medicina Legal y Judicial. -
 En algunos países hay centros de toxicología judicial, pero lo más frecuente es que los análisis toxicológicos de interés legal se realicen en los laboratorios de Medicina Legal.
En algunos países hay centros de toxicología judicial, pero lo más frecuente es que los análisis toxicológicos de interés legal se realicen en los laboratorios de Medicina Legal. -
Se destaca a Emilio Astolfi (1930-1995), médico
argentino, que puede considerarse el padre de la Toxicología en este continente, fue el pionero, fundador y formador de la primera
cátedra de Toxicología en la Facultad de Medicina de la Universidad de Buenos Aires (Argentina), donde actualmente se ofrecen cursos a nivel de pregrado y posgrado de especialización y maestrías desde hace muchos años -
 En Cuba se tiene referencia de manifestaciones tóxicas en el ser humano, ocurridas en el siglo XV entre los aborígenes, ocasionadas por la inhalación de gran cantidad de tabaco (Nicotiana tabacum), lo cual producía embriaguez y alucinaciones, en las que decían que habían hablado con el Semi, nombre que en la Isla los indígenas le
En Cuba se tiene referencia de manifestaciones tóxicas en el ser humano, ocurridas en el siglo XV entre los aborígenes, ocasionadas por la inhalación de gran cantidad de tabaco (Nicotiana tabacum), lo cual producía embriaguez y alucinaciones, en las que decían que habían hablado con el Semi, nombre que en la Isla los indígenas le
daban a sus ídolos, moldeados en barro de manera grosera y tosca. -
En la época actual se evidencia un incremento en la disponibilidad y exposición a sustancias tóxicas de origen químico, animal y vegetal, que colocan a la población mundial en constante riesgo para la salud.
Looking for a timeline maker?
Create timelines for projects, roadmaps, history, lessons, legal cases, and stories with Timetoast. Timetoast is a timeline maker for work, school, research, and stories.

